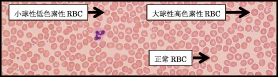
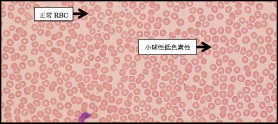

「長距離走」と「かくれ貧血」
| 東区・郡元支部 (デイジークリニック) 武元 良整 |
|---|
3月5日(日)は第2回鹿児島マラソンが開催されます。この原稿を準備している今,街のあちこちで走る人を見かける一方で「貧血はないと診断されたが走れない」と訴える長距離ランナーの来院が増えます。2月になって上記症状で来院の2症例を呈示いたします。
症 例 1:16歳,高校1年の陸上部,男性
主 訴:1カ月前から感じる走った後の「倦怠感」と「下肢の冷え」。
背 景:毎日20kmの長距離練習。寮生活,食事の好き嫌いなし。
病 歴:上記主訴にて来院。4年間陸上部だが,これまで貧血症状は自覚せず。
理学所見:身長165cm,体重52kg,眼瞼結膜に貧血なく,黄疸も認めない。
漢方問診:日中に眠気がある,体が重い(気虚+水滞),よく眠れない(血虚)。
漢方腹証:小腹不仁あり。
末梢血検査:CBC(complete blood count)では貧血なし。
血液生化学検査:血清フェリチン値はランナーとしてはやや低値(30.5ng/mL),血清ビタミンB12値は286pg/mL(基準値180-914)と同様に低値,葉酸値は8.2ng/mL(基準値4以上)。さらに,血清ハプトグロビン低値(測定不能と報告)にて行軍血色素尿症と診断。慢性溶血性貧血のため,鉄欠乏状態を示す典型的なスポ-ツ貧血でした。ビタミンB12は500以上あると疲労感が消えますが,286では低値にて倦怠感を感じると考えられます。治療はビタミンB12静注で開始。葉酸も造血にともなう消耗が見込まれるため1カ月間内服としました。人参養栄湯内服も開始。
最終診断:1.行軍血色素尿症(血清ハプトグロビン:測定不可),2.広義のかくれ貧血(潜在性鉄欠乏状態をかくれ貧血と定義。それは低フェリチン[12.0以下]の事1))
| 検査結果 |
| RBC:497万/μL,Hb:15.7g/dL,MCV(mean corpuscular volume:平均赤血球容積):92.8f L,MCH(mean corpuscular hemoglobin:平均赤血球血色素値):31.6pg,PLT(血小板数):23.3万/μL |
|
| 図 1 末梢血液像:RBC形態はほぼ正球性正色素性で,大小不同をわずかに認めるのみ。 MCV:92.8と正常値(90.0)から判断すると軽度,大球性の傾向。 (末梢血液画像は鹿児島市医師会臨床検査センター血液検査室へ依頼し撮影いただきました) |
症 例 2:16歳,高校1年の陸上部,男性
主 訴:走っていて後半に体が動かなくなる。
背 景:毎日3時間の長距離練習。寮生活,好き嫌いなし。
病 歴:小学校でサッカー,中学校で野球部,高校で陸上部。既往歴なし。
理学所見:身長175cm,体重58kg,眼瞼結膜に貧血なく,黄疸も認めない。
漢方問診:疲労感と日中に眠気,体が重い(気虚+水滞),お腹がグーグー鳴る(気鬱)。
腹 証:胸脇苦満も小腹不仁もなし。
末梢血検査:CBCでは貧血なし。
血液生化学検査:血清フェリチン値は70.4 ng/mL,血清ビタミンB12値は371pg/mL(基準値180-914)と症例1と同様にやや低値,葉酸値は40.7ng/mL(基準値4以上),これは葉酸サプリ内服中と自己申告あり。血清ハプトグロビンは正常値(73,2-2型)にて行軍血色素尿症は否定。ビタミンB12低値を認め,症例1と同様に広義のかくれ貧血と診断1)。治療はビタミンB12静注で開始し,治療の翌日には最後まで走れたとの事。胸脇苦満を認めないため,漢方内服(人参養栄湯)を併用しました。
最終診断:1.行軍血色素尿症は血清ハプトグロビン正常にて否定,2.広義のかくれ貧血(鉄欠乏状態軽度,ビタミンB12低値)
| 検査結果 |
| RBC:478万/μL,Hb:14.8g/dL,MCV:89.5f L,MCH:31.0pg,PLT:24.5万/μL |
|
| 図 2 末梢血液像:RBC形態は小球性低色素性RBCが目立つ。大小不同を認める。 (末梢血液画像は鹿児島市医師会臨床検査センター血液検査室へ依頼し撮影いただきました) |
<中学・高校生,15症例:陸上部>
貧血症状などで受診した陸上部の15症例を表1と表2に示します。全例で「血清ハプトグロビン」を測定しました。受診理由は「倦怠感」「疲労感」「ベストの記録がでない」「たちくらみ」「お風呂で倒れる」「走れない」などでした。注目したい点は,貧血(Hb12.0未満)症例は4例です。ところが,73%にあたる11例は貧血と診断されていません。ビタミンB12の基準値は180以上ですが,来院の15症例はビタミンB12値が205から455の範囲で基準値内です。全員が500以下であった事から,自覚症状が出やすいのはビタミンB12が500以下と考えられました。
まとめ:1.15例中6例,40%が「行軍血色素尿症」,2.明らかな貧血例は26.6%,Hbが12.0未満は4例/15例中,3.低フェリチン(フェリチン:12以下)は同様に33.3%,5例/15例,4.15例のビタミンB12値は205から455(500以下),5.広義の潜在性鉄欠乏状態(低フェリチン:3.9から79.0),6.症状の改善にはフェリチン値を検査しながら鉄剤およびビタミンB12の補充が有用。
最後に,陸上競技者の,かくれ貧血診断には低フェリチンだけでなく,ビタミンB12の低下傾向に注目し500以下であれば,補充する事で症状改善に有用と考えます1,2)。
 |
 |
文 献
1.武元良整:かくれ貧血:Silent Anemia,鹿児島市医報第56巻第1号(通巻659号):46-47,2017
2.武元良整:「倦怠感・たちくらみ」とビタミンB12欠乏,鹿児島市医報第56巻第2号(通巻660号):66-67,2017
(C)Kagoshima City Medical Association 2017